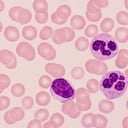
El leucocito de la izquierda con un núcleo ovalado es un linfocito, una importante célula inmunitaria. Los dos leucocitos a la derecha del linfocito son los neutrófilos. Por lo general, tienen un núcleo segmentado o lobulado. Los neutrófilos son excelentes células fagocíticas que engullen partículas o microorganismos dañinos. Los Trombocitos están en la esquina superior derecha, son muy importantes en la trombosis o coagulación de la sangre. Las células teñidas de rosa son eritrocitos, carecen de núcleo, de ahí la palidez central, contienen grandes cantidades de moléculas de hemoglobina y transportan oxígeno. Este es un frotis de sangre normal usando la tinción de Wright.

El hipo es un movimiento involuntario (espasmo) del diafragma, el músculo que se encuentra en la base de los pulmones y a cada contracción le sigue un cierre repentino de las cuerdas vocales, lo cual produce el característico sonido de ‘hip’, de acuerdo con Medline Plus, la Biblioteca Nacional de Medicina de Estados Unidos.
Además, Mayo Clinic, entidad sin ánimo de lucro dedicada a la práctica clínica, la educación y la investigación, explicó que el hipo puede deberse a una comida abundante, bebidas alcohólicas o gaseosas, o una emoción repentina.
Por ello, el diario español Mundo Deportivo reveló, en su sección de salud, trucos para quitar el hipo fácil y rápido en menos de cinco minutos:
1. Aguantar la respiración por 20 minutos.
2. Respirar por la boca de forma constante y seguida.

3. Respirar por la nariz y estirar los brazos hacia el cielo.
4. Tomar zumo de limón.
5. Beber agua fría.
6. Reírse.
7. Comer una cucharadita de de algún alimento dulce como, por ejemplo, azúcar, crema de cacao, miel, entre otros.
No obstante, el hipo que dura más de 48 horas puede deberse a una variedad de factores que se pueden agrupar en las siguientes categorías:
Lesión o irritación a los nervios
Una causa del hipo prolongado es el daño o la irritación de los nervios vagos o frénicos que asisten al músculo del diafragma. Algunos factores que pueden causar daño o irritación en esos nervios son:
- Un pelo o algo en el oído que toca la membrana del tímpano.
- Un tumor, quiste o bocio en el cuello.
- Reflujo gastroesofágico.
- Dolor de garganta o laringitis.
Trastornos del sistema nervioso central
Un tumor o una infección en el sistema nervioso central o daños en el sistema nervioso central como resultado de un traumatismo pueden alterar el control normal del cuerpo sobre el reflejo del hipo. Por ejemplo:
- Encefalitis.
- Meningitis.
- Esclerosis múltiple.
- Accidente cerebrovascular.
- Lesión cerebral traumática.
- Tumores.
Trastornos metabólicos y drogas:
El hipo prolongado puede estar desencadenado por:
- Alcoholismo.
- Anestesia.
- Barbitúricos.
- Diabetes.
- Desequilibrio de electrolitos.
- Enfermedad renal.
- Esteroides.
- Tranquilizantes.

De hecho, explicó que los hombres son mucho más propensos a padecer hipo prolongado que las mujeres, pero otros factores que pueden aumentar el riesgo de hipo son:
- Problemas mentales o emocionales. Se han asociado algunos casos de hipo breve y prolongado con la ansiedad, el estrés y la emoción.
- Cirugía. Algunas personas tienen hipo luego de recibir anestesia general o de procedimientos que involucran órganos abdominales.
Sobre el tratamiento, la entidad sin ánimo de lucro señaló que en la mayoría de los casos, el hipo desaparece por sí solo sin tratamiento médico, pero si el hipo tiene origen en una enfermedad preexistente, el tratamiento contra dicha enfermedad puede eliminarlo.
Además, el médico puede recomendar inyectar un anestésico para bloquear el nervio frénico con el fin de detener el hipo.
Asimismo, la entidad sin ánimo de lucro reveló que otra opción consiste en implantar quirúrgicamente un dispositivo que funciona con batería para brindar una estimulación eléctrica leve al nervio vago. Este procedimiento se utiliza más frecuentemente para tratar la epilepsia, pero también ha servido para controlar el hipo persistente.

De igual forma, indicó que los medicamentos que podrían utilizarse para tratar el hipo prolongado comprenden los siguientes:
- Baclofeno.
- Clorpromazina.
- Metoclopramida.
De todos modos, la información antes dada de ninguna manera sustituye la asesoría médica y por ello lo primero que hay que hacer es consultar a un experto de la salud para que sea este quien guíe el proceso e indique qué es lo más adecuado para cada persona.
